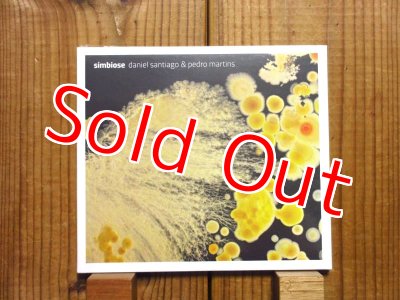

カートローゼンウィンケルが「世界が驚くニュースター」と送り出す、次世代ジャズギタリスト待望の2019年作!■Pedro Martins / Vox [HEARTCORE RECORDS - MOCLD -1016]
カートローゼンウィンケルが「世界が驚くニュースター」と送り出す、次世代ジャズギタリスト待望の2019年作!■Pedro Martins / Vox
[HEARTCORE RECORDS - MOCLD -1016]
販売価格: 2,484円(税込)
在庫1
商品詳細
■新品/国内盤。
■盤質/ジャケット:S 未開封品。
ご存知ブラジルは世界最高峰のギター王国であり、昔からガットギターの名手は、バーデンパウエルをはじめ、ジスモンチ、タパジョス、ハファエルハベーロ、ヤマンドゥコスタ等など…超絶ギタリストがわんさか居たのだが、しかし、ここ最近は、コンテンポラリー系ジャズギタリストが、急激に増えてきている。Nヴェラスをはじめ、Vゴメス、Cピネイロ、Fドナシメント、Lレイチ、Gカストロ、Gファンチ、Cヒベイロ、Rロペス等など…しかも物凄いレベルの高いギタリストばかり!何故、急に増えてきたのかは、不明だが…そのうちジャズギター界の未来はブラジル人が席巻する?、と言っても過言ではないかも知れない。
その中で頭一つ抜け出ている代表格が、ペドロマルチンス。
あのカートローゼンウィンケルの新作「カイピ」の共同プロデューサー/ヴォイスとして重要な役割を果たした、今最も注目のブラジル人ギタリストのペドロマルチンスの記念すべきデビュー作。モントルージャズ・フェスティバルのギタリスト・コンペティションを勝ち抜き、今や世界中から注目を集める若干23歳の天才ギタリスト兼コンポーザー。
本作は、2ndアルバムにあたる2019年作品。カートローゼンウィンケルが「世界が驚くニュースター」と断言し自身のレーベル「ハートコア」から満を持して送り出す待望の新作。ブラッドメルドー、クリスポッター、アントニオロウレイロ、そして勿論カートローゼンウィンケルもギターほか、共同プロデュースとして参加。
ご存知ブラジルは世界最高峰のギター王国であり、昔からガットギターの名手は、バーデンパウエルをはじめ、ジスモンチ、タパジョス、ハファエルハベーロ、ヤマンドゥコスタ等など…超絶ギタリストがわんさか居たのだが、しかし、ここ最近は、コンテンポラリー系ジャズギタリストが、急激に増えてきている。Nヴェラスをはじめ、Vゴメス、Cピネイロ、Fドナシメント、Lレイチ、Gカストロ、Gファンチ、Cヒベイロ、Rロペス等など…しかも物凄いレベルの高いギタリストばかり!何故、急に増えてきたのかは、不明だが…そのうちジャズギター界の未来はブラジル人が席巻する?、と言っても過言ではないかも知れない。
その中で頭一つ抜け出ている代表格が、ペドロマルチンス。
あのカートローゼンウィンケルの新作「カイピ」の共同プロデューサー/ヴォイスとして重要な役割を果たした、今最も注目のブラジル人ギタリストのペドロマルチンスの記念すべきデビュー作。モントルージャズ・フェスティバルのギタリスト・コンペティションを勝ち抜き、今や世界中から注目を集める若干23歳の天才ギタリスト兼コンポーザー。
本作は、2ndアルバムにあたる2019年作品。カートローゼンウィンケルが「世界が驚くニュースター」と断言し自身のレーベル「ハートコア」から満を持して送り出す待望の新作。ブラッドメルドー、クリスポッター、アントニオロウレイロ、そして勿論カートローゼンウィンケルもギターほか、共同プロデュースとして参加。
1. Esqueça (feat. Kurt Rosenwinkel)
2. Faces (feat. Chris Potter)
3. Nova Maneira
4. K7 dreams
5. Horizonte
6. Vida
7. B Side
8. Nao Me Diga Nao (feat. Kurt Rosenwinkel)
9. Verdade (feat. Kurt Rosenwinkel)
10. Vênus 13
11. Origem (feat. Brad Mehldau)
12. Sertão Profundo (feat. Kurt Rosenwinkel)
13. Quem eu sou
14.Voce Entende(ボーナストラック)
Pedro Martins : guitars, voice, piano/synths, bass, drums, percussion, flute, lyrics, songwriting and arrangements
Kurt Rosenwinkel : guitar (esqueça, sertão profundo, verdade, não me diga não), voice (esqueça, sertão profundo), percussion (origem)
Antônio Loureiro : drums (sertão profundo, verdade (R), horizonte, vênus 13, nova maneira), percussion (sertão profundo, origem, vênus 13), voice (sertão profundo), lyrics (vênus 13)
Frederico Heliodoro : bass (sertão profundo, vênus 13, origem, nova maneira), voice (sertão profundo)
Brad Mehldau : piano (origem)
Chris Potter : tenor saxophone (faces)
Kyle Crane : drums (esqueça)
Oscar Azevedo : voice (não me diga não)
Produced by Kurt Rosenwinkel and Pedro Martins
co-produced by Paul Stacey.
track “b side” co-produced by Jake Smith
mixed by Paul Stacey at Strangeways Studios
mastered by Glenn Schick
artwork by Felipe Cavalcante and Gabriel Menezes
cover photo by Michaela Bóková
■盤質/ジャケット:S 未開封品。
ご存知ブラジルは世界最高峰のギター王国であり、昔からガットギターの名手は、バーデンパウエルをはじめ、ジスモンチ、タパジョス、ハファエルハベーロ、ヤマンドゥコスタ等など…超絶ギタリストがわんさか居たのだが、しかし、ここ最近は、コンテンポラリー系ジャズギタリストが、急激に増えてきている。Nヴェラスをはじめ、Vゴメス、Cピネイロ、Fドナシメント、Lレイチ、Gカストロ、Gファンチ、Cヒベイロ、Rロペス等など…しかも物凄いレベルの高いギタリストばかり!何故、急に増えてきたのかは、不明だが…そのうちジャズギター界の未来はブラジル人が席巻する?、と言っても過言ではないかも知れない。
その中で頭一つ抜け出ている代表格が、ペドロマルチンス。
あのカートローゼンウィンケルの新作「カイピ」の共同プロデューサー/ヴォイスとして重要な役割を果たした、今最も注目のブラジル人ギタリストのペドロマルチンスの記念すべきデビュー作。モントルージャズ・フェスティバルのギタリスト・コンペティションを勝ち抜き、今や世界中から注目を集める若干23歳の天才ギタリスト兼コンポーザー。
本作は、2ndアルバムにあたる2019年作品。カートローゼンウィンケルが「世界が驚くニュースター」と断言し自身のレーベル「ハートコア」から満を持して送り出す待望の新作。ブラッドメルドー、クリスポッター、アントニオロウレイロ、そして勿論カートローゼンウィンケルもギターほか、共同プロデュースとして参加。
ご存知ブラジルは世界最高峰のギター王国であり、昔からガットギターの名手は、バーデンパウエルをはじめ、ジスモンチ、タパジョス、ハファエルハベーロ、ヤマンドゥコスタ等など…超絶ギタリストがわんさか居たのだが、しかし、ここ最近は、コンテンポラリー系ジャズギタリストが、急激に増えてきている。Nヴェラスをはじめ、Vゴメス、Cピネイロ、Fドナシメント、Lレイチ、Gカストロ、Gファンチ、Cヒベイロ、Rロペス等など…しかも物凄いレベルの高いギタリストばかり!何故、急に増えてきたのかは、不明だが…そのうちジャズギター界の未来はブラジル人が席巻する?、と言っても過言ではないかも知れない。
その中で頭一つ抜け出ている代表格が、ペドロマルチンス。
あのカートローゼンウィンケルの新作「カイピ」の共同プロデューサー/ヴォイスとして重要な役割を果たした、今最も注目のブラジル人ギタリストのペドロマルチンスの記念すべきデビュー作。モントルージャズ・フェスティバルのギタリスト・コンペティションを勝ち抜き、今や世界中から注目を集める若干23歳の天才ギタリスト兼コンポーザー。
本作は、2ndアルバムにあたる2019年作品。カートローゼンウィンケルが「世界が驚くニュースター」と断言し自身のレーベル「ハートコア」から満を持して送り出す待望の新作。ブラッドメルドー、クリスポッター、アントニオロウレイロ、そして勿論カートローゼンウィンケルもギターほか、共同プロデュースとして参加。
1. Esqueça (feat. Kurt Rosenwinkel)
2. Faces (feat. Chris Potter)
3. Nova Maneira
4. K7 dreams
5. Horizonte
6. Vida
7. B Side
8. Nao Me Diga Nao (feat. Kurt Rosenwinkel)
9. Verdade (feat. Kurt Rosenwinkel)
10. Vênus 13
11. Origem (feat. Brad Mehldau)
12. Sertão Profundo (feat. Kurt Rosenwinkel)
13. Quem eu sou
14.Voce Entende(ボーナストラック)
Pedro Martins : guitars, voice, piano/synths, bass, drums, percussion, flute, lyrics, songwriting and arrangements
Kurt Rosenwinkel : guitar (esqueça, sertão profundo, verdade, não me diga não), voice (esqueça, sertão profundo), percussion (origem)
Antônio Loureiro : drums (sertão profundo, verdade (R), horizonte, vênus 13, nova maneira), percussion (sertão profundo, origem, vênus 13), voice (sertão profundo), lyrics (vênus 13)
Frederico Heliodoro : bass (sertão profundo, vênus 13, origem, nova maneira), voice (sertão profundo)
Brad Mehldau : piano (origem)
Chris Potter : tenor saxophone (faces)
Kyle Crane : drums (esqueça)
Oscar Azevedo : voice (não me diga não)
Produced by Kurt Rosenwinkel and Pedro Martins
co-produced by Paul Stacey.
track “b side” co-produced by Jake Smith
mixed by Paul Stacey at Strangeways Studios
mastered by Glenn Schick
artwork by Felipe Cavalcante and Gabriel Menezes
cover photo by Michaela Bóková